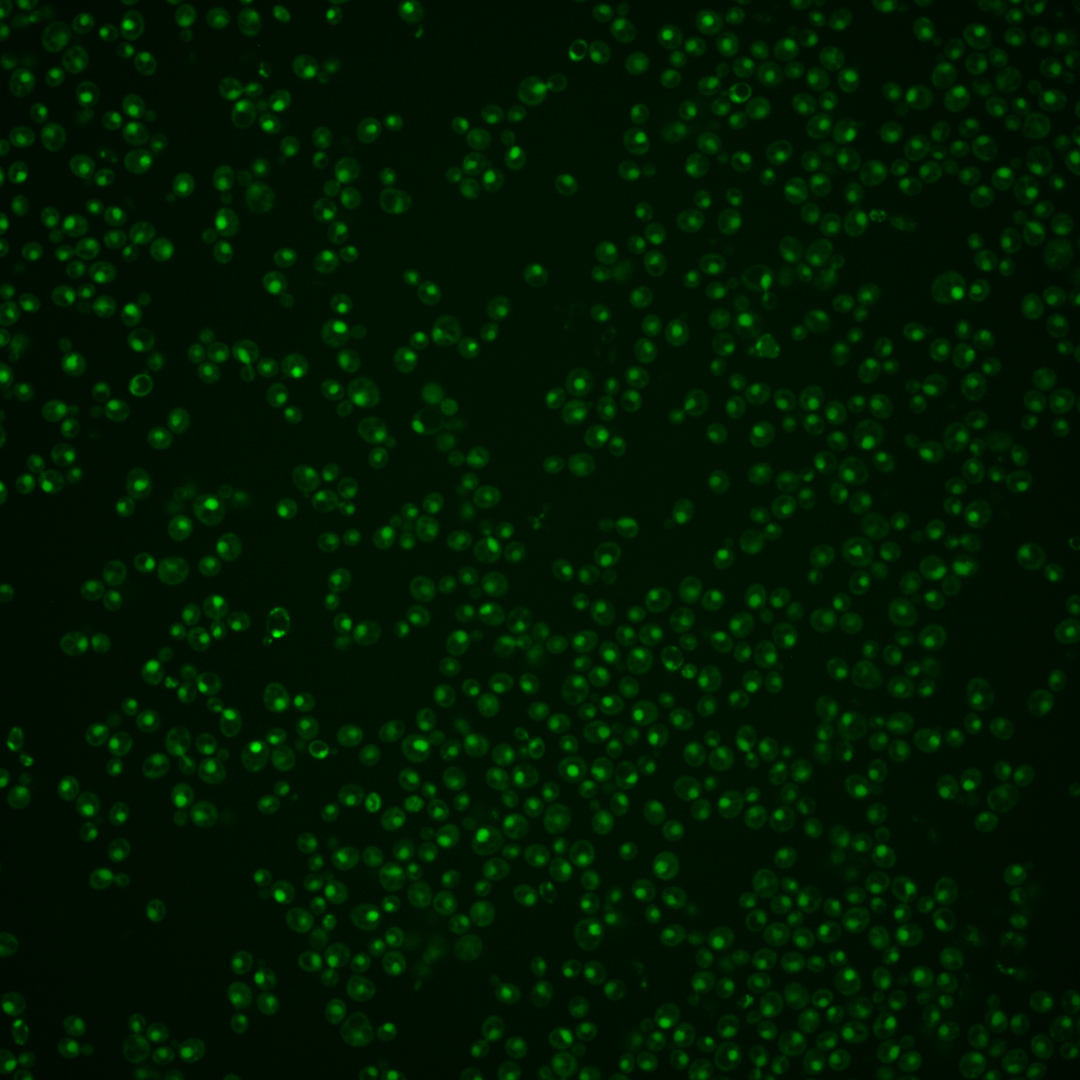

| Standard name | |
|---|---|
| Human Ortholog | |
| Description | Catalytic subunit of DNA polymerase (II) epsilon; a chromosomal DNA replication polymerase that exhibits processivity and proofreading exonuclease activity; participates in leading-strand synthesis during DNA replication; also involved in DNA synthesis during DNA repair; interacts extensively with Mrc1p |
Micrographs




















































































Sub-cellular Localization
Yeast GFP Assignment
Protein Abundance
Localization Change
External localization resources
| ensLOC | DeepLoc | |||||||||||||||||||||||
|---|---|---|---|---|---|---|---|---|---|---|---|---|---|---|---|---|---|---|---|---|---|---|---|---|
| Localization | WT1 | WT2 | WT3 | RAP60 | RAP140 | RAP220 | RAP300 | RAP380 | RAP460 | RAP540 | RAP620 | RAP700 | HU80 | HU120 | HU160 | rpd3Δ_1 | rpd3Δ_2 | rpd3Δ_3 | WT1 | WT2 | WT3 | AF100 | AF140 | AF180 |
| Cortical Patches | 0 | 0 | 0 | 0 | 0 | 0 | 0 | 0 | 0 | 0 | 0 | 0 | 0 | 0 | 0 | 1 | 0 | 0 | 0 | 0 | 0 | 0 | 3 | 1 |
| Bud | 0 | 0 | 0 | 0 | 0 | 5 | 2 | 5 | 3 | 6 | 5 | 6 | 0 | 1 | 0 | 0 | 1 | 1 | 0 | 5 | 2 | 0 | 3 | 1 |
| Bud Neck | 0 | 0 | 0 | 0 | 0 | 0 | 0 | 0 | 0 | 0 | 1 | 0 | 0 | 0 | 0 | 0 | 0 | 0 | 0 | 1 | 0 | 0 | 0 | 0 |
| Bud Site | 0 | 0 | 0 | 9 | 7 | 17 | 8 | 17 | 29 | 24 | 11 | 13 | 0 | 0 | 3 | 0 | 0 | 0 | – | – | – | – | – | – |
| Cell Periphery | 0 | 0 | 1 | 0 | 0 | 0 | 0 | 0 | 0 | 0 | 0 | 0 | 0 | 0 | 0 | 0 | 0 | 0 | 0 | 0 | 0 | 0 | 0 | 0 |
| Cytoplasm | 3 | 5 | 9 | 16 | 15 | 18 | 16 | 23 | 17 | 17 | 10 | 11 | 29 | 37 | 43 | 14 | 16 | 22 | 0 | 1 | 2 | 0 | 0 | 2 |
| Endoplasmic Reticulum | 0 | 0 | 1 | 3 | 0 | 0 | 0 | 0 | 0 | 0 | 0 | 1 | 0 | 0 | 0 | 6 | 2 | 6 | 0 | 0 | 0 | 0 | 1 | 0 |
| Endosome | 2 | 1 | 1 | 0 | 1 | 0 | 1 | 0 | 1 | 0 | 0 | 0 | 2 | 1 | 1 | 2 | 2 | 0 | 3 | 1 | 3 | 1 | 2 | 3 |
| Golgi | 0 | 0 | 0 | 0 | 0 | 0 | 0 | 0 | 0 | 0 | 0 | 0 | 0 | 1 | 1 | 0 | 1 | 2 | 2 | 0 | 4 | 0 | 2 | 2 |
| Mitochondria | 5 | 44 | 83 | 106 | 26 | 160 | 221 | 310 | 296 | 330 | 200 | 259 | 3 | 1 | 26 | 3 | 4 | 3 | 5 | 5 | 6 | 0 | 4 | 6 |
| Nucleus | 277 | 259 | 416 | 364 | 396 | 353 | 507 | 529 | 367 | 400 | 189 | 236 | 196 | 184 | 161 | 171 | 129 | 153 | 264 | 261 | 408 | 154 | 230 | 149 |
| Nuclear Periphery | 3 | 1 | 1 | 3 | 6 | 5 | 6 | 4 | 3 | 8 | 2 | 1 | 1 | 1 | 2 | 2 | 4 | 2 | 0 | 0 | 0 | 0 | 2 | 0 |
| Nucleolus | 6 | 2 | 1 | 4 | 1 | 18 | 20 | 37 | 27 | 30 | 12 | 12 | 11 | 10 | 12 | 2 | 1 | 1 | 3 | 0 | 4 | 1 | 11 | 7 |
| Peroxisomes | 0 | 0 | 0 | 0 | 1 | 0 | 0 | 0 | 0 | 0 | 0 | 0 | 0 | 1 | 1 | 0 | 0 | 0 | 0 | 0 | 0 | 0 | 4 | 0 |
| SpindlePole | 0 | 1 | 0 | 0 | 2 | 4 | 1 | 8 | 4 | 1 | 2 | 0 | 0 | 4 | 0 | 2 | 1 | 0 | 0 | 1 | 1 | 1 | 1 | 2 |
| Vac/Vac Membrane | 2 | 7 | 4 | 5 | 10 | 5 | 5 | 7 | 6 | 8 | 4 | 10 | 8 | 7 | 8 | 14 | 14 | 10 | 7 | 9 | 25 | 11 | 44 | 50 |
| Unique Cell Count | 287 | 286 | 440 | 405 | 430 | 433 | 603 | 658 | 471 | 516 | 271 | 349 | 236 | 236 | 229 | 204 | 162 | 185 | 291 | 290 | 463 | 173 | 315 | 235 |
| Labelled Cell Count | 298 | 320 | 517 | 510 | 465 | 585 | 787 | 940 | 753 | 824 | 436 | 549 | 250 | 248 | 258 | 217 | 175 | 200 | 291 | 290 | 463 | 173 | 315 | 235 |
Yeast GFP Assignment
Protein Abundance
| Screen | WT1 | WT2 | WT3 | RAP60 | RAP140 | RAP220 | RAP300 | RAP380 | RAP460 | RAP540 | RAP620 | RAP700 | HU80 | HU120 | HU160 | rpd3Δ_1 | rpd3Δ_2 | rpd3Δ_3 | AF100 | AF140 | AF180 |
|---|---|---|---|---|---|---|---|---|---|---|---|---|---|---|---|---|---|---|---|---|---|
| Mean Cell GFP Intensity (1e-4) | 7.7 | 5.4 | 4.9 | 4.6 | 5.5 | 4.3 | 4.2 | 4.0 | 3.6 | 3.5 | 3.5 | 3.3 | 6.6 | 6.0 | 5.2 | 9.1 | 10.4 | 10.5 | 6.2 | 6.3 | 6.5 |
| Std Deviation (1e-4) | 1.3 | 1.1 | 1.0 | 1.2 | 1.5 | 1.1 | 1.0 | 1.0 | 1.4 | 1.3 | 1.1 | 1.2 | 1.6 | 1.4 | 1.3 | 2.3 | 3.6 | 3.0 | 1.1 | 1.2 | 1.4 |
| Intensity Change (Log2) | – | – | – | -0.08 | 0.18 | -0.17 | -0.23 | -0.29 | -0.42 | -0.46 | -0.46 | -0.56 | 0.44 | 0.3 | 0.1 | 0.91 | 1.09 | 1.11 | 0.34 | 0.38 | 0.43 |
Localization Change
| Localization | RAP60 | RAP140 | RAP220 | RAP300 | RAP380 | RAP460 | RAP540 | RAP620 | RAP700 | HU80 | HU120 | HU160 | rpd3Δ_1 | rpd3Δ_2 | rpd3Δ_3 |
|---|---|---|---|---|---|---|---|---|---|---|---|---|---|---|---|
| Cortical Patches | 0 | 0 | 0 | 0 | 0 | 0 | 0 | 0 | 0 | 0 | 0 | 0 | 0 | 0 | 0 |
| Bud | 0 | 0 | 0 | 0 | 0 | 0 | 0 | 0 | 0 | 0 | 0 | 0 | 0 | 0 | 0 |
| Bud Neck | 0 | 0 | 0 | 0 | 0 | 0 | 0 | 0 | 0 | 0 | 0 | 0 | 0 | 0 | 0 |
| Bud Site | 0 | 0 | 0 | 0 | 0 | 0 | 0 | 0 | 0 | 0 | 0 | 0 | 0 | 0 | 0 |
| Cell Periphery | 0 | 0 | 0 | 0 | 0 | 0 | 0 | 0 | 0 | 0 | 0 | 0 | 0 | 0 | 0 |
| Cytoplasm | 1.6 | 1.3 | 1.8 | 0.6 | 1.4 | 1.4 | 1.2 | 1.3 | 1.0 | 5.5 | 6.7 | 7.7 | 3.1 | 4.3 | 5.2 |
| Endoplasmic Reticulum | 0 | 0 | 0 | 0 | 0 | 0 | 0 | 0 | 0 | 0 | 0 | 0 | 0 | 0 | 0 |
| Endosome | 0 | 0 | 0 | 0 | 0 | 0 | 0 | 0 | 0 | 0 | 0 | 0 | 0 | 0 | 0 |
| Golgi | 0 | 0 | 0 | 0 | 0 | 0 | 0 | 0 | 0 | 0 | 0 | 0 | 0 | 0 | 0 |
| Mitochondria | 0 | -5.7 | 0 | 0 | 0 | 0 | 0 | 0 | 0 | -6.5 | -6.9 | -2.5 | -6.0 | -5.1 | -5.7 |
| Nucleus | -2.5 | -1.4 | -5.9 | -5.2 | -6.6 | -7.2 | -7.4 | -9.0 | -9.9 | -4.9 | -6.5 | -8.6 | -4.5 | -5.5 | -4.7 |
| Nuclear Periphery | 0 | 0 | 0 | 0 | 0 | 0 | 0 | 0 | 0 | 0 | 0 | 0 | 0 | 0 | 0 |
| Nucleolus | 0 | 0 | 0 | 0 | 0 | 0 | 0 | 0 | 0 | 0 | 0 | 0 | 0 | 0 | 0 |
| Peroxisomes | 0 | 0 | 0 | 0 | 0 | 0 | 0 | 0 | 0 | 0 | 0 | 0 | 0 | 0 | 0 |
| SpindlePole | 0 | 0 | 0 | 0 | 0 | 0 | 0 | 0 | 0 | 0 | 0 | 0 | 0 | 0 | 0 |
| Vacuole | 0 | 1.7 | 0 | 0 | 0 | 0 | 0.9 | 0 | 2.1 | 0 | 0 | 0 | 4.3 | 0 | 0 |
External localization resources
Images






























Protein Concentration and Protein Localization Data
| R1 | R2 | R3 | ||||||||||||||||
|---|---|---|---|---|---|---|---|---|---|---|---|---|---|---|---|---|---|---|
| G1 Pre-START | G1 Post-START | S/G2 | Metaphase | Anaphase | Telophase | G1 Pre-START | G1 Post-START | S/G2 | Metaphase | Anaphase | Telophase | G1 Pre-START | G1 Post-START | S/G2 | Metaphase | Anaphase | Telophase | |
| Concentration | 4.6731 | 5.9438 | 6.0367 | 5.3828 | 5.0285 | 5.3788 | 2.103 | 1.9854 | 2.2097 | 1.4764 | 1.1888 | 1.6781 | 6.0855 | 6.3069 | 6.7519 | 6.2766 | 6.5129 | 6.318 |
| Actin | 0.0349 | 0.0013 | 0.0106 | 0.0639 | 0.0014 | 0.0096 | 0.0463 | 0 | 0 | 0 | 0.0532 | 0.0073 | 0.0049 | 0 | 0 | 0 | 0 | 0.0001 |
| Bud | 0.0002 | 0.0012 | 0.0003 | 0.0006 | 0.0003 | 0.0004 | 0.0004 | 0.0001 | 0 | 0 | 0.0013 | 0.0004 | 0.0006 | 0 | 0 | 0 | 0 | 0 |
| Bud Neck | 0.0003 | 0.0003 | 0.0004 | 0.0127 | 0.0026 | 0.0023 | 0.0019 | 0.0001 | 0 | 0.0001 | 0.0004 | 0.0013 | 0.0015 | 0 | 0 | 0 | 0.0004 | 0.0004 |
| Bud Periphery | 0.0004 | 0.0011 | 0.0004 | 0.0012 | 0.0003 | 0.0008 | 0.0003 | 0.0001 | 0 | 0 | 0.0016 | 0.0015 | 0.0013 | 0 | 0 | 0 | 0 | 0.0001 |
| Bud Site | 0.001 | 0.0079 | 0.0054 | 0.0183 | 0.0023 | 0.0055 | 0.0058 | 0.0001 | 0 | 0 | 0.0014 | 0.0007 | 0.0009 | 0 | 0 | 0 | 0 | 0.0001 |
| Cell Periphery | 0.0001 | 0.0001 | 0.0001 | 0.001 | 0.0002 | 0.0002 | 0.0001 | 0 | 0 | 0 | 0.0001 | 0.0001 | 0.0003 | 0 | 0 | 0 | 0 | 0 |
| Cytoplasm | 0.0028 | 0.0022 | 0.0004 | 0.0175 | 0.0027 | 0.0008 | 0.0289 | 0.0001 | 0.0001 | 0.0001 | 0.0011 | 0.0005 | 0.0124 | 0.0002 | 0.0001 | 0.0001 | 0.0001 | 0.0003 |
| Cytoplasmic Foci | 0.025 | 0.0017 | 0.0013 | 0.0095 | 0.0086 | 0.0018 | 0.0661 | 0 | 0 | 0 | 0.0012 | 0.0024 | 0.0067 | 0 | 0 | 0 | 0 | 0.0011 |
| Eisosomes | 0.0003 | 0.0001 | 0.0001 | 0.0011 | 0 | 0.0001 | 0.0001 | 0 | 0 | 0 | 0.0002 | 0.0001 | 0.0001 | 0 | 0 | 0 | 0 | 0 |
| Endoplasmic Reticulum | 0.0012 | 0.0004 | 0.0005 | 0.0022 | 0.0026 | 0.0009 | 0.0031 | 0 | 0 | 0 | 0.0023 | 0.0011 | 0.0056 | 0 | 0 | 0 | 0 | 0.0003 |
| Endosome | 0.0103 | 0.0015 | 0.0103 | 0.0061 | 0.0148 | 0.0067 | 0.0184 | 0 | 0 | 0 | 0.0084 | 0.0065 | 0.0103 | 0 | 0 | 0 | 0 | 0.0014 |
| Golgi | 0.0047 | 0.0006 | 0.0032 | 0.0059 | 0.0012 | 0.0044 | 0.0075 | 0 | 0 | 0 | 0.0069 | 0.0033 | 0.0047 | 0 | 0 | 0 | 0 | 0.0003 |
| Lipid Particles | 0.0086 | 0.0007 | 0.0036 | 0.01 | 0.0044 | 0.0036 | 0.0259 | 0 | 0 | 0 | 0.0004 | 0.0022 | 0.0724 | 0 | 0 | 0 | 0 | 0.0105 |
| Mitochondria | 0.0276 | 0.0032 | 0.0199 | 0.031 | 0.0033 | 0.0057 | 0.0013 | 0.001 | 0.0003 | 0.0001 | 0.01 | 0.0249 | 0.005 | 0.0001 | 0.0002 | 0.0002 | 0.0005 | 0.0009 |
| None | 0.0029 | 0.0062 | 0.0002 | 0.004 | 0.0018 | 0.0002 | 0.0023 | 0 | 0 | 0 | 0.0005 | 0.0003 | 0.0006 | 0 | 0 | 0 | 0 | 0.0003 |
| Nuclear Periphery | 0.0018 | 0.0043 | 0.0036 | 0.0107 | 0.0155 | 0.0089 | 0.0221 | 0.0017 | 0.0035 | 0.0059 | 0.0033 | 0.0137 | 0.0574 | 0.0011 | 0.001 | 0.0066 | 0.0011 | 0.0048 |
| Nucleolus | 0.0059 | 0.0067 | 0.0049 | 0.0027 | 0.0292 | 0.0156 | 0.0389 | 0.0136 | 0.0098 | 0.0051 | 0.0163 | 0.0224 | 0.0107 | 0.0068 | 0.0057 | 0.0031 | 0.017 | 0.0084 |
| Nucleus | 0.851 | 0.9555 | 0.9302 | 0.777 | 0.8956 | 0.9252 | 0.6577 | 0.9742 | 0.9861 | 0.9885 | 0.8894 | 0.8976 | 0.7852 | 0.9882 | 0.9927 | 0.9895 | 0.98 | 0.9675 |
| Peroxisomes | 0.0084 | 0.0012 | 0.0016 | 0.013 | 0.0006 | 0.0008 | 0.0282 | 0 | 0 | 0 | 0.0004 | 0.0009 | 0.0055 | 0 | 0 | 0 | 0 | 0.0005 |
| Punctate Nuclear | 0.0116 | 0.0026 | 0.0006 | 0.0085 | 0.0074 | 0.0034 | 0.0429 | 0.0088 | 0.0001 | 0.0001 | 0.0006 | 0.0096 | 0.0067 | 0.0034 | 0.0001 | 0.0002 | 0.0005 | 0.0019 |
| Vacuole | 0.0005 | 0.001 | 0.0016 | 0.0011 | 0.0039 | 0.002 | 0.0012 | 0.0001 | 0 | 0 | 0.0005 | 0.0014 | 0.0041 | 0 | 0 | 0.0001 | 0.0001 | 0.0005 |
| Vacuole Periphery | 0.0004 | 0.0003 | 0.001 | 0.0019 | 0.0012 | 0.0012 | 0.0005 | 0.0001 | 0.0001 | 0 | 0.0006 | 0.0018 | 0.0033 | 0 | 0 | 0.0002 | 0.0001 | 0.0005 |
Sequencing Data
| R1 | R2 | |||||||||
|---|---|---|---|---|---|---|---|---|---|---|
| G1 Post-START | S/G2 | Metaphase | Anaphase | Telophase | G1 Post-START | S/G2 | Metaphase | Anaphase | Telophase | |
| Gene Expression | 43.3486 | 20.8546 | 11.6337 | 21.9994 | 41.938 | 34.0644 | 20.8991 | 16.1494 | 19.1779 | 48.1245 |
| Translational Efficiency | 0.6542 | 0.545 | 0.4396 | 0.4164 | 0.4379 | 0.6812 | 0.4841 | 0.326 | 0.3451 | 0.4285 |
Hit Data
| Dataset | Hit |
|---|---|
| Protein Concentration | ✘ |
| Protein Localization | ✘ |
| Gene Expression | ✔ |
| Translational Efficiency | ✔ |
Endocytosis
| Temp | Actin Patch (Sac6-tdTomato) | Cortical Patch (Sla1-GFP) | Late Endosome (Snf7-GFP) | Vacuole (Vph1-GFP) |
|---|---|---|---|---|
| 37℃ | ||||
| RT |
Cell Cycle Omics
CYCLoPs (Pol2-GFP)
| Gene / Allele | Actin Patch (Sac6-tdTomato) | Cortical Patch (Sla1-GFP) | Late Endosome (Snf7-GFP) | Vacuole (Sac6-tdTomato) |
|---|
| Gene | Images |
|---|
| Gene | Images |
|---|
Images are not yet available
Images are not yet available